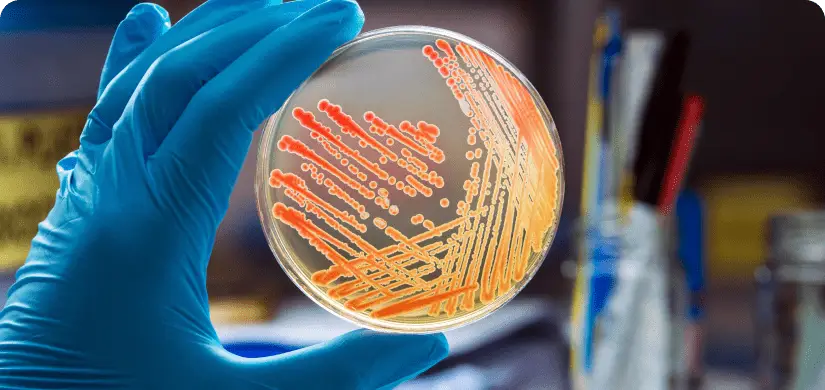
Nitrile Gloved hand holding culture smear on petri dish.

Training Reimagined
Food Safety Training Catalog
Train your workforce through virtual workshops and eLearning modules. Receive certifications needed for compliance with HACCP, PCQI, FSMA, and other regulatory standards.

Virtual Instructor-Led
Learn regulatory compliance, food safety standards, proper operating procedures, and fundamentals of sanitation and hygiene from top food industry experts.
The course curriculum is based on the guidelines from the Consumer Brands Association in conjunction with the FDA. IEH Academy is a recognized BPCS provider. This two or three day food safety training course is offered by IEH’s processing experts who have extensive experience in aseptic, high acid, and retort operations and teaching.
- June 16-18th, 2026
- Virtual Instructor-Led
- Dr. Robert Brackett, Dr. Gene Bartholomew, Mark Deniston, Dr. Peter Ferstl
The course curriculum is based on the guidelines from the Food Safety Preventive Controls Alliance (FSPCA) in conjunction with the FDA. Group panels & discussions will be utilized through virtual breakout rooms which will reinforce knowledge and allow students to share experiences.
- October 19-23, 2026
- Instructor-Led
- Dr. Peyman Fatemi
IEH Academy’s HACCP training is accredited by the International HACCP Alliance and meets USDA, FDA, CFIA, and GFSI HACCP training requirements.
This two-day, live virtual course provides participants with the critical knowledge to develop, implement, and maintain an effective HACCP plan.
- 16 Hours
- Instructor-Led
- Dr. Gene Bartholomew
This course is specifically designed for all those involved in thermal processing. It covers all of the essential information regarding the preservation of food products by heat, including thermobacteriology, heat penetration theory, ball calculation procedures, and more.
- 16 Hours
- Instructor-Led
- Dr. Gene Bartholomew, Mark Deniston, Randy Porter
This course discusses thermobacteriology as it is applied to food processing. With a focus on the methods of process evaluation, special attention will be given to fundamental concepts on which the development of the methods is based.
- 3 Hours
- Instructor-Led
- Dr. Gene Bartholomew
The AFDO Seafood HACCP Alliance course provides participants with the information needed to develop their firm’s Seafood HACCP plan. Those who complete both Segments are eligible for a “Certificate of Course Completion” from the Association of Food and Drug Officials (AFDO). This certificate provides evidence that the individual meets the training requirements.
- 8 Hours
- Instructor-Led
- Dr. George Baker
This training explains the key sanitary design principles for facilities and food processing equipment to support food safety, and to allow effective and efficient sanitation of the equipment and the facility.
- 8 Hours
- Instructor-Led
- Randy Porter
This course is designed to cover compost sampling requirements. It covers the number of samples, how and where to take the samples, and why they are being taken. After successfully completing this course, a certificate will be issued to each participant.
- 1 Hour
- Instructor-Led
- Dr. Sam Myoda
This course is designed to give the participant a comprehensive understanding of the importance of a robust environmental monitoring program. It also covers proper sampling techniques, where to sample and frequency of sampling, target organisms and methods. Finally, it covers the responses to testing data, e.g., implementing corrective actions, documentation and data management.
- 1 Hour
- Instructor-Led
- Dr. Sam Myoda
This course is designed to cover food safety risks, regulatory & customer requirements, field & water sampling as well as sample transport. After successfully completing this course, a certificate will be issued to each participant.
- 1 Hour
- Instructor-Led
- Dr. Sam Myoda
eLearning Courses
Follow along in these guided self paced eLearning modules curated by industry experts and professionals in food safety.
Reliable laboratory results depend on consistent procedures, proper documentation, equipment control, and effective oversight. Weak laboratory practices can compromise the integrity of results, regulatory compliance, and overall product confidence. This course provides an overview of Good Laboratory Practices (GLPs).
- 99.00
- 1 Hour
- Self Paced eLearning
- Dr. Suf Alkhaldi
Product specifications function as the central reference point for how a product is defined, produced, and controlled across operations. The course addresses key elements including product identity, ingredient and allergen controls, labeling requirements, and the distinction between Ready-to-Eat (RTE) and Cook-Before-Eating (CBE) foods.
- 99.00
- 1 Hour
- Self Paced eLearning
- Dr. Suf Alkhaldi
Reliable laboratory results depend on consistent procedures, proper documentation, equipment control, and effective oversight. Weak laboratory practices can compromise the integrity of results, regulatory compliance, and overall product confidence. This course provides an overview of Good Laboratory Practices (GLPs).
- 49.00
- 30 Mins
- Self Paced eLearning
- Thomas Hammack
Environmental monitoring helps verify that food production environments remain sanitary and do not introduce pathogens into food products. Selecting appropriate microorganisms is an important part of an Environmental Monitoring Program (EMP) and should be based on product risks, processing conditions, and regulatory expectations.
- 49.00
- 30 Mins
- Self Paced eLearning
- Dr. Gene Bartholomew
This course explains the regulatory and scientific considerations for reconditioning adulterated food products. When a product is determined to be adulterated, options may include recall, detention, or destruction unless reconditioning can be demonstrated to restore the product to a safe and compliant condition.
- 69.00
- 45 Mins
- Self Paced eLearning
- Thomas Hammack
Partnering with a food copacker does not transfer legal responsibility for food safety or regulatory compliance. Under 21 CFR 117, brand owners remain accountable for approving, verifying, and documenting copacker performance within their supplier approval program. This course examines FDA expectations, common compliance failures, and the oversight and documentation systems necessary to control risk and maintain regulatory compliance.
- 69.00
- 45 Mins
- Self Paced eLearning
- Dr. Suf Alkhaldi
Chemical hazards—whether naturally occurring or introduced during food production and processing—can pose significant risks to consumers and result in costly recalls, regulatory action, and reputational damage for food producers. This course provides a practical overview of chemical hazards in foods, grounded in toxicology principles and regulatory expectations.
- 99.00
- 1 Hour
- Self Paced eLearning
- Dr. Gene Bartholomew
Primary food-contact materials are critical to food safety, product integrity, and regulatory compliance. This course provides a practical overview of how the FDA regulates materials that directly contact food, including bottles, caps, films, cans, paper, and recycled plastics, and how these requirements apply within food manufacturing operations. Participants will review FDA expectations for food-contact substances, including GMP, documentation, supplier approval, and proper storage and handling.
- 69.00
- 45 Mins
- Self Paced eLearning
- Dr. Suf Alkhaldi
This course provides a clear, practical overview of key FDA food regulations found in Title 21 CFR. Participants will review major regulatory requirements, including Part 117 (Preventive Controls), Parts 113 and 114 (Low-Acid Canned Foods and Acidified Foods), Part 108 (emergency permit), Bioterrorism Act (What Food Facilities Must Do), and other critical regulations (101, 120, FSVP) that support food safety and regulatory compliance.
- 99.00
- 1 Hour
- Self Paced eLearning
- Dr. Suf Alkhaldi
This course provides a practical overview of the Ball Formula Calculation Method used to determine thermal process time and lethality in low-acid canned foods. Participants review the underlying theory, key parameters, and application of the method, including interpretation of heat penetration data and calculation of heating and cooling factors. The course also examines the method’s advantages and limitations, as well as how it compares with other thermal process calculation approaches.
- 49.00
- 30 Mins
- Self Paced eLearning
- Mark Deniston
Contractor activities can introduce significant food safety and compliance risks if not properly managed. This course provides a structured framework for approving and monitoring contractors, including pre-qualification, required documentation, GMP expectations, tool and chemical controls, and supervision of maintenance or construction activities.
- 99.00
- 1 Hour
- Self Paced eLearning
- Dr. Suf Alkhaldi
Method validation ensures that food testing methods are reliable, accurate, and compliant with regulatory requirements. This course explains when full validation, verification, or matrix extension is required—based on FDA, AOAC, and ISO guidance. Participants will learn how to determine the appropriate level of validation for a given testing scenario to ensure their testing method aligns with regulatory expectations and method requirements.
- 49.00
- 30 Mins
- Self Paced eLearning
- Thomas Hammack
Lab contamination is uncommon, but the consequences can be significant. From costly recalls to the destruction of otherwise safe products.
This course outlines how lab errors occur, how to identify them, and what steps companies can take to mitigate risk. Participants will examine case studies, common contamination pathways, and strategies for working with in-house and contract labs to manage unexpected positive results with confidence.
- 49.00
- 30 Mins
- Self Paced eLearning
- Thomas Hammack
Sanitizers are critical for controlling pathogens. Yet misuse and environmental pressures can allow bacteria to adapt, leading to resistance, persistent contamination, and costly outbreaks.
This course examines the drivers of sanitizer resistance, with a particular focus on Listeria. It also explains how resistance to commercial sanitizers occurs among other microorganisms, such as Salmonella, E. coli, and Staphylococcus.
- 99.00
- 1 Hour
- Self Paced eLearning
- Dr. Suf Alkhaldi
The General Method (GM) is a widely used calculation procedure for thermal process operations that ensures food safety by using actual time–temperature data to determine lethality through the area under the lethal rate curve. This course provides an introduction to the GM approach, covering its theoretical basis, practical application, and key tools.
- 49.00
- 30 Mins
- Self Paced eLearning
- Mark Deniston
This course provides a practical framework for developing Quality Assurance and Quality Control (QA/QC) systems that align with FDA requirements, including FSMA, 21 CFR 117, and HACCP. Participants will learn how to prepare for FDA audits, reduce the risk of recalls and 483s, and build defensible SOPs, accurate records, and meaningful metrics that protect both food safety and brand integrity.
- 49.00
- 30 Mins
- Self Paced eLearning
- Dr. Suf Alkhaldi
Contractors and maintenance crews support the operation of food production facilities, but their activities can introduce significant food safety risks if not properly managed.
This course provides practical guidance on preventing contamination during construction, repairs, or equipment servicing in food environments.
- 99.00
- 1 Hour
- Self Paced eLearning
- Dr. Gene Bartholomew
This course covers key frameworks for managing consumer complaints in accordance with FDA regulations. It examines how effective complaint handling contributes to increased customer satisfaction and long-term loyalty. Participants will gain a clear understanding of FDA requirements and learn how to reduce regulatory risk through structured, well-documented response strategies.
- 49.00
- 30 Mins
- Self Paced eLearning
- Dr. Suf Alkhaldi
The FDA’s Food Traceability Final Rule is designed to improve food safety and outbreak response by requiring detailed traceability records for certain high-risk foods. This course covers the rule’s core components, including (CTEs), (KDEs), and (TLCs), along with guidance for developing a written Traceability Plan. Be prepared to meet the January 2026 compliance deadline.
- 49.00
- 30 Mins
- Self Paced eLearning
- Dr. Gene Bartholomew
The Pasteurized Milk Ordinance (PMO) establishes safety standards for Grade “A” milk and milk products, ensuring public health protection and industry compliance. This course explores the history, regulatory framework, and key requirements of the PMO and its role in interstate milk shipments and food safety enforcement.
- 49.00
- 30 Mins
- Self Paced eLearning
- John Allan
Temperature distribution testing ensures even temperature distribution in retort systems, preventing underprocessing and ensuring food safety. This course covers the principles of temperature distribution, factors affecting heat uniformity, and testing methods used to verify retort performance.
- 99.00
- 1 Hour
- Self Paced eLearning
- Mark Deniston
This course offers a comprehensive understanding of product recall regulations, focusing on FDA and USDA-FSIS guidelines to ensure consumer safety. Attendees will learn to manage recalls and withdrawals effectively, maintain regulatory compliance, and minimize public health risks.
- 149.00
- 1.5 Hours
- Self Paced eLearning
- Dr. Suf Alkhaldi & Carol Cave
This course provides a practical guide to conducting internal food safety audits, covering effective techniques, regulatory expectations, and common industry challenges. Participants will develop the skills to confidently assess food safety systems, document findings, and implement corrective actions to ensure compliance and continuous improvement at their facility.
- 49.00
- 30 Mins
- Self Paced eLearning
- Dr. Gene Bartholomew
This course provides a comprehensive overview of aseptic processing and packaging systems. Participants will explore the fundamental principles of system operations, the regulatory requirements, and the critical role of the aseptic zone in maintaining sterility.
- 99.00
- 1 Hour
- Self Paced eLearning
- Mark Deniston
Sanitation verification is at the heart of food safety and quality. This course covers the most effective verification methods, including visual inspections, chemical and microbiological testing, and ATP testing. These methods are critical for maintaining both preoperative and operational sanitation standards, ensuring their effectiveness and safety throughout each stage of production.
- 99.00
- 1 Hour
- Self Paced eLearning
- Dr. Gene Bartholomew
Ensuring food safety requires reliable microbiological testing that meets regulatory standards. This course provides a comprehensive understanding of the FDA’s role in method validation, its involvement with organizations like AOAC, and the conditions under which specific methods are required.
- 99.00
- 1 Hour
- Self Paced eLearning
- Thomas Hammack
Salmonella is one of the most significant challenges in food production, contributing to widespread illnesses and substantial economic losses each year. This course is designed to provide food producers, quality assurance professionals, and regulatory personnel with essential knowledge about Salmonella, including its characteristics, sources, and control methods.
- 49.00
- 30 Mins
- Self Paced eLearning
- Dr. Gene Bartholomew
This course covers essential concepts of heat transfer in canned foods and provides the expertise needed to design effective heat penetration tests. Participants will learn about different heating methods — conduction, convection, and induced convection — and the testing equipment used in the field.
- 49.00
- 30 Mins
- Self Paced eLearning
- Mark Deniston
This course provides a clear understanding of the critical concepts of validation and verification, both essential for ensuring safe and compliant food production. It covers the definitions, differences, regulatory requirements, and practical steps for applying these concepts in food safety processes such as HACCP and sanitation.
- 99.00
- 1 Hour
- Self Paced eLearning
- Dr. Gene Bartholomew
This comprehensive course provides an overview of FDA and USDA food labeling claims. Participants will gain a clear understanding of the regulatory frameworks governing food labeling, including FDA nutrient content, health, and structure/function claims, as well as USDA Organic and Bioengineered labeling requirements.
- 199.00
- 2 Hours
- Self Paced eLearning
- Alton Bradshaw
This course equips food industry professionals with the critical knowledge and practices needed to prevent intentional adulteration in food production and supply.
Participants will examine the critical role of food defense in protecting consumers, maintaining brand integrity, and meeting both government and global safety standards.
- 49.00
- 30 Mins
- Self Paced eLearning
- Dr. Gene Bartholomew
This course provides a comprehensive understanding of FDA regulatory requirements, focusing on inspection protocols, compliance strategies, and managing forms such as 482 and 483. Attendees will learn practical approaches to responding to FDA observations, interpreting warning letters, and navigating consent decrees.
- 199.00
- 2 Hours
- Self Paced eLearning
- Carol Cave, Dr. Suf Alkhaldi
Six Sigma statistical techniques are exceptionally effective for high-volume food and beverage manufacturing. In this course, we cover case studies demonstrating how data-driven decisions can enhance cost efficiency, quality, food safety, and productivity.
- 99.00
- 1 Hour
- Self Paced eLearning
- Ruth Pierson
This course offers a comprehensive overview, equipping attendees with the knowledge to meet inspection standards and ensure smooth interactions with both management and the FDA. FDA Form 3623 is a critical tool used by FDA Investigators during farm inspections.
- 49.00
- 30 Mins
- Self Paced eLearning
- Dr. Suf Alkhaldi
This course will guide you through the selection and usage of gaskets in the food and beverage industry. Learn the main factors of gasket material selection to determine compatibility for your equipment. Troubleshoot gasket issues and plan preventative maintenance tasks with the right frequency.
- 49.00
- 30 Mins
- Self Paced eLearning
- Ruth Pierson
In this course, we will cover the use of peroxide in aseptic systems including typical consumption trends and seasonal issues. We also provide troubleshooting recommendations for investigating and resolving peroxide concentration issues.
- 49.00
- 30 Mins
- Self Paced eLearning
- Ruth Pierson
This course will guide you through the essential factors that influence thermal processing, focusing on their impact on product quality and process efficiency. You’ll learn to identify key elements in retort and aseptic systems, making informed decisions to optimize safety and performance in your operations.
- 49.00
- 30 Mins
- Self Paced eLearning
- Mark Deniston
This course provides a solid overview and covers the primary key elements associated with the most popular third-party NGO food labeling certification in the United States: Kosher. This course should be beneficial for regulatory labeling personnel, plant quality managers, brand marketing managers, and professionals who want to understand what kosher certification involves before considering pursuing an individual kosher certification for a finished product and/or plant.
- 49.00
- 30 Mins
- Self Paced eLearning
- Alton Bradshaw
Understanding how to manage foreign materials is critical for ensuring the safety and quality of food products. This course equips participants with practical strategies and programs to reduce risks associated with foreign material contamination, empowering them to contribute to a safer food production environment.
- 99.00
- 1 Hour
- Self Paced eLearning
- Dr. Gene Bartholomew
The course offers a comprehensive overview of the top ten non-government food labeling claims used in the US. It is tailored primarily for regulatory food labeling specialists, attorneys seeking to expand their expertise in non-government food labeling claims requirements, product development scientists, and plant quality managers responsible for food labeling.
- 49.00
- 30 Mins
- Self Paced eLearning
- Alton Bradshaw
Controlling food safety risks is a critical task for all food producers and processors. Extensive evidence and regulatory adoption have shown the system known as Hazard Analysis Critical Control Point (HACCP) is a fundamentally sound way to develop a food safety process.
This course is designed to provide the tools to help trainees become important partners in the food safety system.
- 99.00
- 1 Hour
- Self-Paced eLearning
- Dr. Gene Bartholomew
This eLearning course covers the implementation of effective sensory evaluation techniques that can be leveraged to ensure products meet consumer expectations.
- 149.00
- 1.5 Hours
- Self-Paced eLearning
- Dr. George Baker
This set of eight 15-minute, self-paced online courses will cover the general requirements (manufacturing, processing, packing, and holding operations), Raw Materials and other Ingredients, and the Manufacturing operations.
- 19.99
- 15 Minutes
- Self-Paced eLearning
- Dr. George Baker
Explore the world of microorganisms in the food industry and how microorganisms play a role in food production and manufacturing. Microbes such as bacteria, molds, and yeasts are utilized for foods production.
- 99.00
- 1 Hour
- Self-Paced eLearning
- Dr. Gene Bartholomew
In this course students will learn about the nature of thermal deviations, what information should be included in deviation records and what are best practices for completing deviation record forms.
- 49.00
- 1 Hour
- Self-Paced eLearning
- Mark Deniston
Thermal processes are essential for controlling foodborne microbial hazards and thereby ensuring the safety of the public when consuming food products.
- 99.00
- 1 Hour
- Self-Paced eLearning
- Mark Deniston
Identify characteristics of allergens, lists responsibilities of various departments within the organization, and give a clear road map to proper legislative compliance and active management of allergens within a facility across all functions.
- 149.00
- 1.5 Hours
- Self-Paced eLearning
- Dr. Gene Bartholomew, Cindy Ryan
This course is devoted to teaching sanitation practices and equipment design to eliminate Lm from the processing environment and paying attention to GMPs that may contribute to contamination during processing and traffic patterns that may bring.
- 199.00
- 2 Hours
- Self-Paced eLearning
- Dr. Gene Bartholomew
This course is designed to illustrate the critical role environmental monitoring and sampling plans play in food and beverage processing. Content in this course is curated for those who are responsible for designing, updating, and implementing the elements of an environmental monitoring program in their facility or company.
- 149.00
- 1.5 Hours
- Self-Paced eLearning
- Dr. Gene Bartholomew, Cindy Ryan
This course is designed to give end users the knowledge to understand the benefits and limitations of modified atmosphere packaging, and the basics to work with material and equipment supplies to shorten the development process and enhance desirable product attributes.
- 99.00
- 1 Hour
- Self-Paced eLearning
- Dr. Gene Bartholomew
This course provides an overview of aflatoxin and its big-picture implications for the food and feed supply. This eLearning course offers a comprehensive overview of mycotoxins and their health and economic impact on the food industry. We will look at how contamination is detected and discuss preventative techniques regarding aflatoxin.
- 49.00
- 30 Mins
- Self-Paced eLearning
- Dr. Jack Davis
After taking this course, learners will have a working understanding and appreciation of food corporate culture considerations, including recognizing and evaluating food safety and quality culture, communication strategies for diverse audiences, and management considerations that support a positive food safety and quality culture.
- 99.00
- 1 Hour
- Self-Paced eLearning
- Dr. Robert Brackett
Upon completion of this course, you should understand the advanced aspects of sensory analysis and be able to plan and conduct several sensory analysis protocols based on standard practices and methods used by sensory professionals.
- 399.00
- 4 Hours
- Self-Paced eLearning
- Dr. George Baker
Topics include dry and wet cleaning methods, as well as the types of soils in a food facility and the chemicals and methods required to effectively remove soils and microbes to assure hygienic conditions of the processing equipment and the processing environment.
- 199.00
- 2 Hours
- Self-Paced eLearning
- Randy Porter
This course provides a step-by-step form for a document manager and their team to control the entire food safety and quality document process, from document creation through logical destruction at the appropriate time.
- 49.00
- 30 Mins
- Self-Paced eLearning
- Dr. Gene Bartholomew
This course is designed to provide food company managers with a deeper understanding and awareness of the ethical considerations surrounding production, processing, and distribution of food.
- 99.00
- 1 Hour
- Self-Paced eLearning
- Dr. Robert Brackett
A successful food safety system and culture are, without a doubt, a few of the most important challenges facing all food processors and ancillary businesses. It truly takes a team effort from across many disciplines and responsibilities within a manufacturer, and the procurement or purchasing group is an integral part of this team effort.
- 99.00
- 1 Hour
- Self-Paced eLearning
- Dr. Gene Bartholomew
Pathogens, or harmful microorganisms, are responsible for a large number of foodborne illnesses and deaths in the U.S. every year. Many of these infections come from foods that are considered fully cooked. Food producers need to understand how thermal processing removes pathogens from products and what steps are necessary to ensure a successful heat treatment.
- 199.00
- 2 Hours
- Self Paced eLearning
- Dr. Gene Bartholomew
This course will help you interpret updated USDA guidelines and better understand how to ensure the safety and quality of your RTE meat and poultry products.
- 49.00
- 1 Hour
- Self-Paced eLearning
- Dr. Gene Bartholomew
This course covers introductory information involving the sensory evaluation of food. Upon completion of this course, you should understand the aspects of sensory analysis and be able to assist in developing a sensory program at your company.
- 199.00
- 2 Hours
- Self-Paced eLearning
- Dr. George Baker
Cronobacter sakazakii is a pathogenic bacterium associated with a variety of foods, most notably dried or powdered foods, or environments. This course is designed to provide basic information about Cronobacter and the many factors that are necessary to control Cronobacter in foods or food plants.
- 99.00
- 1 Hour
- Self-Paced eLearning
- Dr. Robert Brackett
If you grow, process or use peanuts as ingredients in products destined for domestic or international consumer markets, questions about ingredient uniformity, ingredient safety and ingredient performance may have come to mind as you work with the seed of this very interesting plant.
- 49.00
- 30 Mins
- Self Paced eLearning
- Dr. Foy Mills, Jr., David Deshazo
Join us for the latest edition of our Peanut 101 eLearning series, In this course, our spotlight turns to the crucial aspect of ingredient uniformity, exploring its direct impact on food safety and the performance of food products.
- 49.00
- 30 Mins
- Self Paced eLearning
- Dr. Foy Mills, Jr., David Deshazo
In this course, we continue our focus on ingredient uniformity and how it leads to food safety and food product performance, specifically addressing growing environment, climate and weather.
- 49.00
- 30 Mins
- Self Paced eLearning
- Dr. Foy Mills, Jr., David Deshazo
This course provides introductory information related to the fermentation of food. The covered topics include the historical context, scientific principles, major types of food fermentation processes and associated microorganisms, categorization of fermented foods, as well as troubleshooting methods and effective solutions.
- 99.00
- 1 Hour
- Self-Paced eLearning
- Dr. Margaret Hardin, Dr. Gene Bartholomew